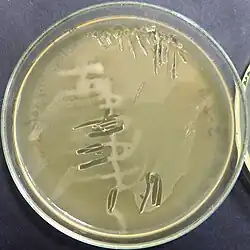

Cosenzaea
Taxonavigation
| Taxonavigation: Enterobacterales |
|---|
|
Prokaryota |
Familia: Morganellaceae
Genus:
Species: C. myxofaciens
Name
Cosenzaea Giammanco et al. 2011, gen. nov.
References
- Giammanco, G.M.; Grimont, P.A.D.; Grimont, F.; Lefevre, M.; Giammanco, G.; Pignato, S.: Phylogenetic analysis of the genera Proteus, Morganella and Providencia by comparison of rpoB gene sequences of type and clinical strains suggests the reclassification of Proteus myxofaciens in a new genus, Cosenzaea gen. nov., as Cosenzaea myxofaciens comb. nov. In: International Journal of Systematic and Evolutionary Microbiology, 2011-07-01, 61:1638-1644. DOI: 10.1099/ijs.0.021964-0
- List of procaryotic names with standing in nomenclature (LPSN): Cosenzaea
- Cosenzaea – Taxon details on National Center for Biotechnology Information (NCBI).
- European Nucleotide Archive